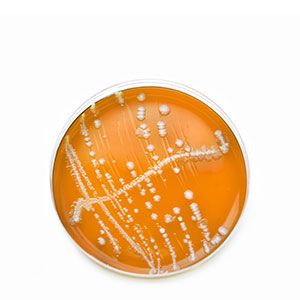

INNOVACIÓN
A la vanguardia en innovación


Investigación, desarrollo e innovación, la hoja de ruta de nuestro crecimiento y una básica en todo lo que hacemos. Es y será siempre nuestra gran diferenciación frente a los competidores.
Desde hace casi cuatro décadas nuestro objetivo principal es ir un paso por delante, explorar nuevos caminos, innovar y ser diferentes. Por ese motivo la investigación, el desarrollo y la innovación son para nosotros una apuesta de futuro. Una apuesta que intenta dar solución a los principales problemas que afectan al sector agroalimentario y por ende a nuestra sociedad.
Gracias una gran inversión anual en investigación y a nuestros profesionales del departamento de I+D, en Fertinagro Biotech podemos presumir de contar ya con casi 150 patentes tecnológicas registradas a nivel nacional e internacional, mientras continuamos desarrollando proyectos fundamentales para la adaptación del agricultor a los nuevos marcos regulatorios.
Estos proyectos se centran en el desarrollo de nuevos productos y procesos que minimicen el uso de los recursos económicos utilizados en la agricultura, poniendo especial énfasis en el desarrollo de fertilizantes eficientes que aumenten los rendimientos de los cultivos utilizando recursos renovables.
DE INVERSIÓN ANUAL EN I+D+i
CON CENTROS DE INVESTIGACIÓN
CERTIFICADOS POR CDTI
EN LOS ÚLTIMOS 15 AÑOS
DE INVESTIGACIÓN
EN CURSO
E INTERNACIONALES
Instalaciones punteras
Los laboratorios más avanzados del sector
Nuestra apuesta constante por la investigación nos ha permitido estar a la vanguardia en innovación, disponiendo de los laboratorios agronómicos y biotecnológicos más completos y avanzados del sector, donde se desarrollan los fertilizantes del futuro.
El desarrollo de las pruebas de I+D se centralizan en el C.I.B.A situado en Utrillas, Teruel, donde contamos con un laboratorio de análisis físico-químico y un laboratorio de biología molecular, cuyas últimas adquisiciones suponen una importante revolución en el campo de la biotecnología. En él realizamos estudios metagenómicos con los que somos capaces de secuenciar el genoma de los diferentes microorganismos presentes en el suelo y, por lo tanto, ver las características de su composición microbiológica.
También disponemos de laboratorio de fisiología vegetal y con la tecnología NIRS para la caracterización de materias primas y fertilizantes minerales en la planta de Teruel.

C.I.B.A: El laboratorio de Agrotecnología más grande de Europa

La investigación como base de una buena estrategia de fertilización
-
Toma de muestras del suelo
-
Primero, tras un estudio preliminar de las características de la parcela y la evolución del cultivo mediante teledetección, se lleva a cabo la toma de muestras de suelo en la parcela a estudiar.
-
-
Aislamiento de ADN
-
En el laboratorio, homogenizamos las submuestras, las cribamos y preparamos para los distintos análisis a realizar aislando el ADN microbiano mediante kits de extracción específicos.
-
-
Secuenciación
-
Con el secuenciador masivo de ADN MiSeq obtenemos información sobre las secuencias genómicas específicas de los microorganismos del suelo para posteriormente procesarlas.
-
-
Ensamblaje
-
Mediante herramientas bioinformáticas se interpretan los resultados y se obtiene una fotografía fiable de la diversidad y estructura de las poblaciones microbianas.
-
-
Identificación
-
A partir de la fotografía obtenida durante las anteriores fases de análisis (secuenciación y ensamblaje) llevaremos a cabo la interpretación de estos resultados.
-
-
Plan de abonado preciso
-
Gracias a la información obtenida en la evaluación del componente biológico del suelo podemos diseñar de planes de fertilización exclusivos y de alta precisión para cada ecosistema concreto.
-
Colaboración con instituciones
Convenios de investigación
-
Universidad de Zaragoza (UZ)
-
Universidad de Barcelona (UB)
-
Universidad Politécnica de Valencia (UPV)
-
Universidad Politécnica de Madrid (UPM)
-
Universidad Autónoma de Madrid (UAM)
-
Instituto de Biología Molecular y Celular de Plantas (IBMCP)
-
Instituto de Ciencia y Tecnología Animal (ICTA-UPV)
-
Institut de Recerca i Tecnologia Agroalimentàries (IRTA)
-
Centro de Edafología y Biología Aplicada del Segura (CEBAS-CSIC)
-
Centro de Investigaciones de Recursos y Consumos Energéticos (CIRCE)
-
Centro de Investigación de Tecnología Animal (CITA-IVIA)
-
Fundación Parque Científico Tecnológico Aula Dei
-
Socio activos de la Plataforma BIOVEGEN (Plataforma Tecnológica de Biotecnología Vegetal).
Saber más > -
-
-
Miembro de la Fundación CIRCE (Centro de Investigación de Recursos y Consumos Energéticos)
Saber más >
Patentes registradas
ACTIVA Y AUMENTA LA DIVERSIDAD DE LAS POBLACIONES DE AZOTOBACTER, PSEUDOMONAS Y BACILLUS A NIVEL FOLIAR Y EDÁFICO
EL AZOTOBACTER CONSIGUE UN EFECTO DE FIJACIÓN Y ASIMILACIÓN DEL NITRÓGENO ATMOSFÉRICO DE MANERA NATURAL
PSEUDOMONAS Y BACILLUS DESBLOQUEAN Y SOLUBILIZAN GRANDES CANTIDADES DE FÓSFORO Y POTASIO PRESENTES EN EL SUELO
LOS MICROORGANISMOS ACTIVAN LAS DEFENSAS RADICULARES DE LA PLANTA CON EFECTOS FUNGISTÁTICOS Y NEMATOSTÁTICOS
Conocimiento compartido
Principales proyectos en curso
AGRIMAX pretende demostrar el potencial de los desechos de productos hortofrutícolas como tomates, patatas, olivas o cereales para contribuir a aumentar la sostenibilidad del sector a nivel europeo.
EMBRACED modelo circular de biorrefinería integrada basado en la valorización de la fracción celulósica de residuos de Productos de Higiene Absorbente (AHP) posconsumo hacia la producción de bloques de construcción de base biológica, polímeros y fertilizantes.
FETIMANURE ejemplo perfecto del modelo de economía circular a través del tamiento de residuos orgánicos provenientes de excrementos de ganadería para hacer fertilizante.
BIOSCHAMP desarrollar un sustrato sostenible alternativo y bioestimulante que reducirá la dependencia y el uso de pesticidas y contribuirá a mejorar la productividad, la sostenibilidad y la rentabilidad en Europa.
SEA2LAND trabajará en la mejora y adaptación de tecnologías de recuperación de nutrientes para producir biofertilizantes a partir de subproductos del procesamiento de pescados y acuicultura
PESTNU Pruebas de campo y demostración de tecnologías digitales y espaciales con agroecología y prácticas orgánicas en innovación sistémica. Centro de Investigación y Tecnología Hellas (CERTH) (Líder).
FERTILIGENCIA Fertilizantes innovadores para reducir el impacto ambiental de la agricultura y desarrollo de un estándar para evaluar la sostenibilidad de agroecosistemas.
RESTOS VEGETALES Reducción de la huella ecológica del purín a través de un tratamiento sostenible, para reducir el coste medioambiental que generan las granjas, haciéndolas más sostenibles, contribuyendo a mejorar la salud ambiental de las poblaciones cercanas, (reducirá la volatilización de amoníaco y otras fuentes de nitrógeno). Cuantificación del porcentaje de reducción de emisiones y desarrollo de un nuevo fertilizante más sostenible y eficiente).
Fertinagro Biotech (coordinadora), Terraibérica Desarrollos, Porcino de Teruel y Crianzas Campovivo, además, UPM, UPV y UNIZAR.
PÉPTIDOS Desarrollo de un nuevo método para la clasificación y valoración de bioestimulantes vegetales. Fertinagro Nutrigenia, Universidad de Barcelona.
CIEN MEDKIDS Investigación y desarrollo de nuevos productos alimentarios para la elaboración de una cesta saludable para alimentación infantil”, desarrollando un snak de proteína híbrida -vegetal y animal-, que guste al consumidor infantil y con el que se pretende prevenir la obesidad de niños y niñas.
CIEN INSECTUM Valorización de subproductos urbanos y biorresiduos mediante bioconversión con insectos para la generación de productos innovadores en sectores estratégicos.
CIEN LOWPH-WINE Estudio de nuevos factores relacionados con el suelo, la planta y la microbiota enológico que influyen en el equilibrio de la acidez de los vinos y en su garantía de calidad y estabilidad en climas cálidos. Participan grandes bodegas como: Pago de Carraovejas, Bodegas Barbadillo, Agrotecnologías Naturales, Agrovin, Vitis Navarra, Bodegas Roda, Hoyada de los Lobos…
NITRIFICACIÓN Desarrollo de nuevas estrategias naturales de inhibición del proceso de nitrificación. UPM, UB.
EcoCalCit Calcio Ecológico Citosólico. INTIA, CNTA.
UNITA – UNIVERSITAS MONTIUM Universidade de Beira Interior, Universidad de Zaragoza, Université de Pau et des Pays de l’Adour, Université Savoie Mont Blanc, Università di Torino y Universitatea de Vest din Timisoara. SOE4/P5/E1059.
AGROGREEN SUDOE Sistemas Agroalimentarios Futuros para una transición social y medioambientalmente sostenible: Co-diseño de estrategias para la mitigación de riesgos medioambientales en aguas y atmósfera en espacios naturales del territorio SUDOE. UPM/CEIGRAM (Spain), UPA (Spain), CNRS (France), Instituto Superior de Agronomía ISA DCEB (Portugal), (ABRVS) Portugal, C hambre d'agriculture de lacharente maritime (FR)




